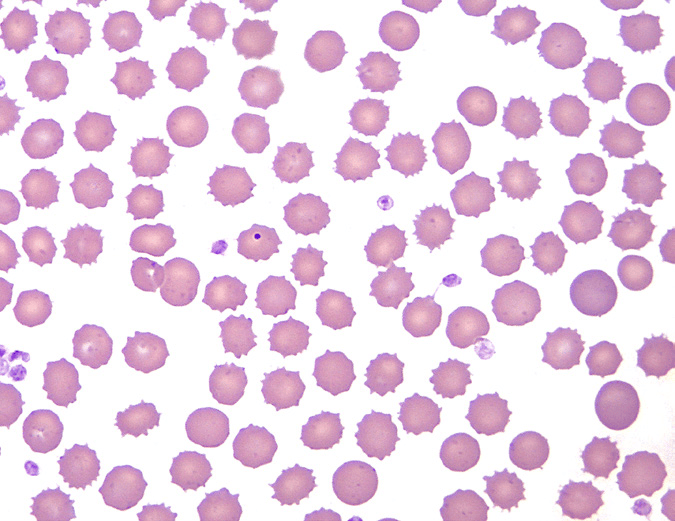
红细胞形态评估:异形红细胞之刺毛细胞,棘红细胞和裂红细胞

新月形红细胞

而镰状细胞病患者的血红细胞是成新月状的
图片尺寸640x426
▼「中幼红细胞」形态特征:胞体呈圆形或椭圆形,胞核圆形,约占细胞的1
图片尺寸750x1000
大小不一的红细胞碎片,有盔形,刺形,三角形,扭曲形,小新月形细胞等
图片尺寸600x910
【检验高频考点复习】红细胞检查之形态学
图片尺寸1920x2560
红细胞形态评估:异形红细胞之刺毛细胞,棘红细胞和裂红细胞
图片尺寸675x521
尿液中正常和异常红细胞形态分享!
图片尺寸1920x2560
2张图片让你彻底学会成熟红细胞形态
图片尺寸1170x1066
地贫|红细胞|血常规|血小板|癌症患者_网易订阅
图片尺寸660x615
一文读懂"尿液红细胞形态分析"
图片尺寸640x875
红细胞计数和血红蛋白不匹配是何故?——血常规助力地贫筛查
图片尺寸660x495
镰刀型细胞贫血,红细胞呈新月形或镰刀形,身体产生异常形状的病
图片尺寸640x427
在出生后由于红细胞膜表面抗原与母体抗体不相容而导致的溶血现象
图片尺寸3024x4032
红细胞会产生一种异常的血红蛋白,导致细胞呈镰刀状或新月形.
图片尺寸916x1034
红细胞形态正常异常
图片尺寸1080x1439
其它 2018年细胞形态学培训考试 a:椭圆红细胞 b: 裂红细胞 c:棘形红
图片尺寸695x464
图3 患者外周血涂片镜检图(箭头所指为球形红细胞)结果显示:成熟红
图片尺寸826x644
镜下红细胞#红细胞 #尿常规异常
图片尺寸1080x1439
溶血|红细胞|血细胞|血常规|hba1c_网易订阅
图片尺寸660x674
那些年,曾经被混淆过的红细胞_手机搜狐网
图片尺寸634x486
一文读懂"尿液红细胞形态分析"
图片尺寸640x794